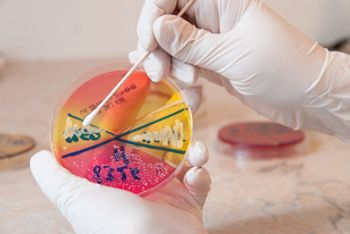

Data from EXPLORE, a prospective, multinational, natural history study, is used to characterize disease activity and clinical management of patients with acute hepatic porphyria (AHP) who experience recurrent attacks. The findings highlight the high unmet need for effective treatments.